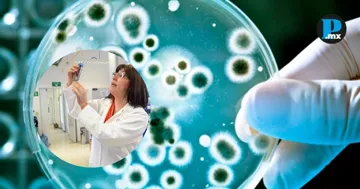

El equipo de investigación del Instituto de Biotecnología de la UNAM descubrió en el Golfo de México bacterias capaces de degradar hidrocarburos y utilizarlos como fuente de energía. Entre 10 y 20 por ciento de los microorganismos analizados presentan esta capacidad, lo que abre nuevas posibilidades para enfrentar la contaminación marina. 
El equipo encabezado por Liliana Pardo López, del Laboratorio de Biotecnología Marina, ha realizado expediciones desde 2015 a bordo del buque oceanográfico Justo Sierra, recolectando muestras desde las costas de Tamaulipas hasta el Caribe, a profundidades de hasta 4 mil metros. Mediante técnicas de metagenómica, los científicos han construido un atlas microbiano del Golfo y cuentan con un cepario de más de 400 bacterias cultivables con capacidad de degradar hidrocarburos. Entre ellas destaca un consorcio bacteriano compuesto por tres especies, incluyendo Alcanivorax, especializada en degradar alcanos. Te puede interesar: Identifican bacteria en el Golfo de México capaz de degradar plástico en 15 días El proceso funciona en cadena: una especie descompone los compuestos más simples del petróleo, mientras las otras aprovechan los productos resultantes. En conjunto, transforman los contaminantes en dióxido de carbono y agua, reduciendo su toxicidad hasta en un 50 por ciento. El proyecto avanza hacia la creación de un laboratorio móvil en Tuxpan, Veracruz, donde se probarán estas bacterias en condiciones más cercanas al ambiente natural. Las líneas futuras incluyen su producción a gran escala, aplicación en ríos contaminados y el desarrollo de robótica marina para llevarlas a sitios de difícil acceso. Los investigadores esperan que este conocimiento derive en protocolos de biorremediación marina, ofreciendo una alternativa científica frente a la contaminación por hidrocarburos. |